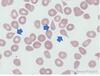
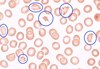
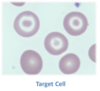
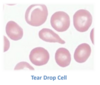
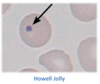

Gejala klasik DM?
Poliuria, polidipsi, polifagi, penurunan bb
Kriteria diagnosis DM?
HbA1C ≥ 6,5
GDP ≥ 126
G2PP ≥ 200
GDS ≥ 200 + GEJALA KLASIK DM
TTGO ≥ 200
Kriteria diagnosis prediabetes?
HbA1C = 5,7 - 6,4
GDP = 100-125
G2PP = 140-199
Kriteria GDPT?
GDP 100-125
TTGO < 140
Kriteria TGT (Toleransi Glukosa Terganggu)
GDP <100
TTGO 140-199
Nilai normal berapa?
Hba1c :
GDP :
GD2PP :
Hba1 c: <5,7
GDP : 70-99
GD2PP : 70-139
Empat pilar tatalaksana DM?
1.
2.
3.
4.
- Edukasi
- Diet
- Aktivitas fisik
- Obat (OHO dan insulin)
golongan Obat DM apa saja ? contoh obatnya?
- insulin sensitizer = metformin, thiazolidinedione
- insulin secretagogue = sulfonilurea, glinid
- DPP-4 inhibitor = alogliptin, linagliptin, dll
- alfa-glukosidase inhibitor = acarbose
- SGLT-2 inhibitor = empagliflozin, dll
Pasien DM, Hba1c <7.5%
Apa tatalaksananya?
Monoterapi:
Metformin
Sulfonilurea/glinid
Alfa glukosidase inhibitor
Tiazolidinedion
DPP4 inhibitor
SGLT 2 inhibitor
Agonis GLP-1
*Bila Hba1c belum mencapai <7% dalam 3 bulan, maka kombinasi 2 obat
Pasien DM, Hba1c nya ≥ 7.5%
Apa tatalaksananya?
Kombinasi 2 obat dengan mekanisme yang berbeda:
Metformin
Sulfonilurea/glinid
Alfa glukosidase inhibitor
Tiazolidinedion
DPP4 inhibitor
SGLT 2 inhibitor
Agonis GLP-1
*Bila Hba1c belum mencapai <7% dalam 3 bulan, maka kombinasi 3 obat
Pasien DM, Hba1c >9%, gejala klinis (-)
apa tatalaksananya?
Kombinasi 2 obat atau kombinasi 3 obat
Metformin
Sulfonilurea/glinid
Alfa glukosidase inhibitor
Tiazolidinedion
DPP4 inhibitor
SGLT 2 inhibitor
Agonis GLP-1
*Bila Hba1c belum mencapai <7% dalam 3 bulan, maka ikuti alur nya
Pasien DM, Hba1c >9%, gejala klinis (+)
apa tatalaksananya?
Insulin ± obat lain
Target terapi DM?
IMT:
TD Sistol :
TD Diastol :
HbA1C:
IMT: 18,5 - 22,9
TD Sistol : <140
TD Diastol : <90
HbA1C: <7
Target terapi DM?
gula darah pre prandial :
gd2pp :
LDL :
Trigliserida :
HDL :
Apo-B :
gula darah pre prandial : 80-130
gd2pp : <180
LDL : <100, <70 bila risiko KV sangat tinggi
Trigliserida : <150
HDL : >40 (laki), >50 (perempuan)
Apo-B : <90
GD2PP≥200 + gejala klasik dm
GDS≥ 200 + gejala klasik dm
C-peptide rendah
Dx?
DM Tipe 1
Hiperglikemia (300-600)
tanda dan gejala asidosis
plasma keton (+)
dx?
KAD
hiperglikemia berat (600-1200)
tanpa tanda da gejala asidosis
osmolaritas plasma meningkat (330-380)
plasma keton (+/-)
dx?
HHS
Tatalaksana krisis hiperglikemia?
- Cairan isotonik
- 1 L/jam Nacl 0.9% - KCL jika hipo/normokalemia
- insulin bolus 0,05-0,1U/kgBB lanjut 0,1 U/kgBB/jam IV drip
- Koreksi HCO3
*pemberian cairan harus melihat status dehidrasinya
- kalo sever hipovolemia= nacl 0,9% 1L/jam
- mild dehydration= evaluasi Na Corrected.
normal atau high Na: pakai 0,45% NacL 250-500ml/jam
low Na = nacl 0.9% (250-500ml/jam)
Corrected Natrium
Koreksi natrium (sodium) pada pasien hiperglikemia adalah perhitungan yang dilakukan untuk memperkirakan kadar natrium yang sebenarnya di dalam darah. Hal ini penting karena kadar glukosa darah yang sangat tinggi (hiperglikemia) dapat memengaruhi hasil pengukuran natrium, membuat kadar natrium yang terukur terlihat lebih rendah (hiponatremia dilusional) dari yang sebenarnya.
Mekanisme Hiponatremia Dilusional
Pada kondisi hiperglikemia, kadar glukosa yang sangat tinggi di dalam pembuluh darah akan meningkatkan osmolaritas plasma. Untuk menyeimbangkan kondisi ini, air dari sel-sel tubuh akan berpindah ke ruang ekstraseluler (di luar sel) melalui proses osmosis. Akibatnya, terjadi pengenceran (dilusi) pada natrium di dalam plasma, sehingga kadar natrium yang terukur menjadi lebih rendah dari seharusnya. Hiponatremia yang terjadi ini disebut sebagai hiponatremia dilusional.
Rumus Koreksi Natrium
Untuk mendapatkan perkiraan kadar natrium yang sebenarnya, digunakan rumus koreksi natrium. Terdapat beberapa versi rumus yang umum digunakan, antara lain:
* Rumus 1: Natrium terkoreksi = Natrium terukur + 1,6 x ((Glukosa terukur - 100) / 100)
* Rumus ini digunakan ketika kadar glukosa terukur antara 100-400 mg/dL.
* Dalam rumus ini, setiap kenaikan kadar glukosa sebesar 100 mg/dL di atas nilai normal (100 mg/dL) akan menyebabkan penurunan natrium serum sekitar 1,6 mEq/L.
* Rumus 2: Natrium terkoreksi = Natrium terukur + 4 x ((Glukosa terukur - 100) / 100)
* Beberapa sumber menyarankan penggunaan faktor 4 ketika kadar glukosa darah lebih dari 400 mg/dL, karena pada kadar ini pergeseran air dari intraseluler ke ekstraseluler lebih signifikan.
Perhitungan natrium terkoreksi ini membantu dokter dalam menilai status hidrasi pasien dan menentukan jenis cairan infus yang paling tepat. Pasien dengan hiperglikemia sering mengalami dehidrasi akibat diuresis osmotik (peningkatan produksi urine), dan koreksi natrium membantu memastikan penanganan yang tidak terlalu agresif atau terlalu lambat.
Anda bisa menonton video How to Correct Sodium in Hyperglycemia untuk memahami lebih lanjut mengenai perhitungan koreksi natrium pada pasien hiperglikemia.
Whipple’s triad hipoglikemia?
1.
2.
3.
- Terdapat gejala hipoglikemia
- GDS< 70 mg
- gejala berkurang dengan pengobatan
Pasien tidak memerlukan bantuan orang lain untuk memberika glukosa oral
Derajat hipoglikemia?
Hipoglikemia ringan
Pasien membutuhkan bantuan orang lain untuk memberika glukosa iv, glukagon, dll.
Derajat hipoglikemia?
Hipoglikemia berat
Tatalaksana Hipoglikemia Ringan?
Glukos 15-20gr (2-3 sendok makan gula pasir) dilarutkan dalam air
Tatalaksana hipoglikemia berat?
D10% 150 ml dalam 15 menit
or
D40% 25-50 ml dalam 15 menit
or
D20% 75-100 ml dalam 15 menit
Maintanance D10% 100ml/jam jika GD sudah mencapai target
Target ≥ 70
Klinis: poliuria, polidipsi
Penunjang:
urinalisa berat jenis urin rendah (<1.005 mOSm)
water deprivation test-> osmolalitas urin tidak berubah
uji desmopressin-> peningkatan osmolalitas urin
Dx?
Central diabetes insipidus